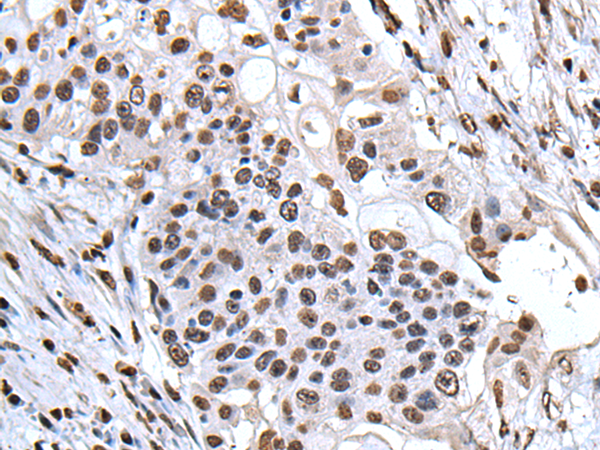

询价单号 点击跳转查看 X

| 编 号 | 规格 | 库存 | 目录价(¥) | 您的价格(¥) | 数 量 |
| D122870-0025 | 25 ul | 现货 | 500 | 500 | |
| D122870-0100 | 100 ul | 现货 | 1600 | 1600 | |
| D122870-0200 | 200 ul | 现货 | 2500 | 2500 |
概述
Implicated in a number of cellular processes, including proliferation, differentiation, caspase-dependent and caspase-independent apoptosis, suppression of transformation (tumor suppressor), inhibition of protein phosphatase 2A, regulation of mRNA trafficking and stability in association with ELAVL1, and inhibition of acetyltransferases as part of the INHAT (inhibitor of histone acetyltransferases) complex. Plays a role in E4F1-mediated transcriptional repression.
应用
酶联免疫吸附测定(ELISA),免疫印迹(WB),免疫组织化学(IHC)
属性
| 保存缓冲液 | -20°C, pH7.4 PBS, 0.05% NaN3, 40% Glycerol |
| 运输条件 | 2-8°C |
| 靶点 Uniprot 登记号 | P39687 |
| 靶点基因 ID | 8125 |
| 靶点全称 | acidic nuclear phosphoprotein 32 family member A |
| 靶点别名 | LANP; MAPM; PP32; HPPCn; PHAP1; PHAPI; I1PP2A; C15orf1 |
| 靶点研究领域 | Cancer, Metabolism |
| 亚型 | Immunogen-specific rabbit IgG |























 精确搜索
精确搜索 我的草稿
我的草稿
 我的购物车
我的购物车

 精确搜索
精确搜索






